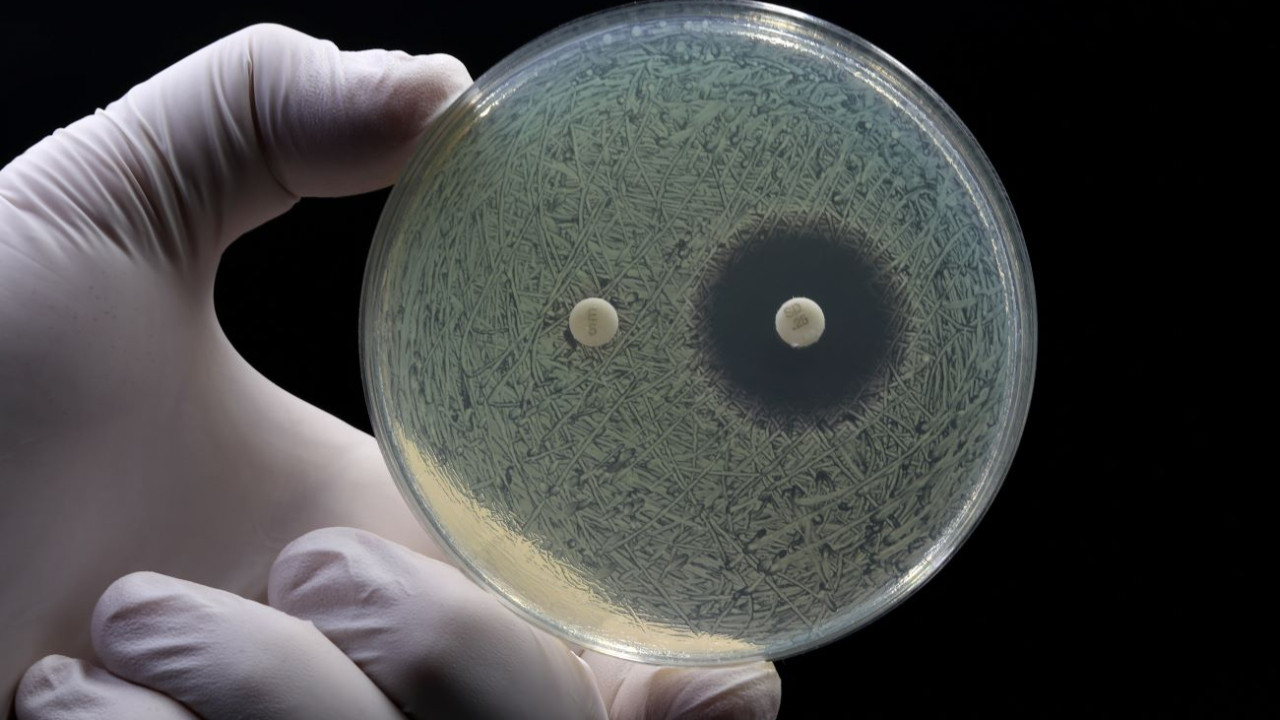
antimikrobiyal-diren-ara-t-rmas-2050-y-l-na-kadar-40-milyon-ki-i

40 Milyon Euro Ne Kadar Tl Trying to find a method to stay organized? Free printable schedules are the best service! Whether you need a daily, weekly, or monthly planner, these templates help you simplify tasks, handle your time, and improve efficiency. Developed for adaptability, they're ideal for work, school, or home usage. Just download, print, and start preparing your days with ease.
With adjustable alternatives, free printable schedules let you customize your strategies to fit your unique requirements. From colorful designs to minimalist designs, there's something for everyone. They're not just practical but likewise a budget-friendly method to monitor consultations, due dates, and goals. Start today and experience the difference a well-organized schedule can make!
40 Milyon Euro Ne Kadar Tl

40 Milyon Euro Ne Kadar Tl
These family tree templates are easy to use Simply print one or more of the family trees below and fill out the boxes with your family names Family tree templates offer a simple way to show future family members where they come from and what their origins are.
Family Tree Templates Pedigree Charts Ancestry

Gram K l e Alt nlar Mayda Alt n
40 Milyon Euro Ne Kadar TlTrace your ancestry and vibrant heritage with online whiteboard templates and tools from Canva's free family tree maker. Our selection of printable family tree templates can be downloaded for free in PDF and Microsoft Word file formats
Use our family tree templates to chart your family relationships. Creating a visual can help you understand the wider family structure and appreciate the ... 1 Pound Ka TL 2023 2 3 4 ngiliz Sterlini Eniyisor Dolar Ka Lira Oldu Euro Ne Kadar 1 Mart 2025 Cumartesi G n G ncel
42 Family Tree Templates for 2018 Free PDF DOC PPT

Model Y
A selection of beautiful professional looking family tree templates free and ready for you to fill in They look so good you ll want to print and frame Wuppermann Avusturya daki Boru Fabrikas na Yat r m Yapacak
You can get family tree templates on our website for free Available in Word Excel and PDF formats Ready to edit and print Download now Milyar Milyon Fark Nedir Onedio 2 Milyon TL Ile En Y ksek Getiriyi Sa layan Bankalar Ekonomi G rsel

100 Euro

Muhasebe Platformu Indy 40 Milyon Euro Yat r m Ald Swipeline

S la n n Annesi Yo un Bak ma Kald r ld

Euro TL Ve Dolar TL Yeni Rekora Imza Att Kamudanhaber nternet Sitesi

Euro Ne Kadar 100 Euro Ka TL Eder D viz Haberleri

Los Vapos Vape Shop In Bonaero Park Shopping CenterVozol Star 6000

40 Euro Ka TL 40 Euro Ne Kadar

Wuppermann Avusturya daki Boru Fabrikas na Yat r m Yapacak

te 1 Milyon Dolar n Masada Kaplad Alan KRT TV
Antimikrobiyal Diren Ara t rmas 2050 Y l na Kadar 40 Milyon Ki i